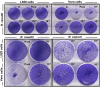

RickA expression is not sufficient to promote actin-based motility of Rickettsia raoultii
- PMID: 18612416
- PMCID: PMC2440523
- DOI: 10.1371/journal.pone.0002582
RickA expression is not sufficient to promote actin-based motility of Rickettsia raoultii
Abstract
Background: Rickettsia raoultii is a novel Rickettsia species recently isolated from Dermacentor ticks and classified within the spotted fever group (SFG). The inability of R. raoultii to spread within L929 cells suggests that this bacterium is unable to polymerize host cell actin, a property exhibited by all SFG rickettsiae except R. peacocki. This result led us to investigate if RickA, the protein thought to generate actin nucleation, was expressed within this rickettsia species.
Methodology/principal findings: Amplification and sequencing of R. raoultii rickA showed that this gene encoded a putative 565 amino acid protein highly homologous to those found in other rickettsiae. Using immunofluorescence assays, we determined that the motility pattern (i.e. microcolonies or cell-to-cell spreading) of R. raoultii was different depending on the host cell line in which the bacteria replicated. In contrast, under the same experimental conditions, R. conorii shares the same phenotype both in L929 and in Vero cells. Transmission electron microscopy analysis of infected cells showed that non-motile bacteria were free in the cytosol instead of enclosed in a vacuole. Moreover, western-blot analysis demonstrated that the defect of R. raoultii actin-based motility within L929 cells was not related to lower expression of RickA.
Conclusion/significance: These results, together with previously published data about R. typhi, strongly suggest that another factor, apart from RickA, may be involved with be responsible for actin-based motility in bacteria from the Rickettsia genus.
Conflict of interest statement
Figures

References
-
- Gouin E, Welch MD, Cossart P. Actin-based motility of intracellular pathogens. Curr Opin Microbiol. 2005;8:35–45. - PubMed
-
- Stevens JM, Galyov EE, Stevens MP. Actin-dependent movement of bacterial pathogens. Nat Rev Microbiol. 2006;4:91–101. - PubMed
-
- Ogata H, Audic S, Renesto-Audiffren P, Fournier PE, Barbe V, et al. Mechanisms of evolution in Rickettsia conorii and R. prowazekii. Science. 2001;293:2093–2098. - PubMed
MeSH terms
Substances
LinkOut - more resources
Full Text Sources